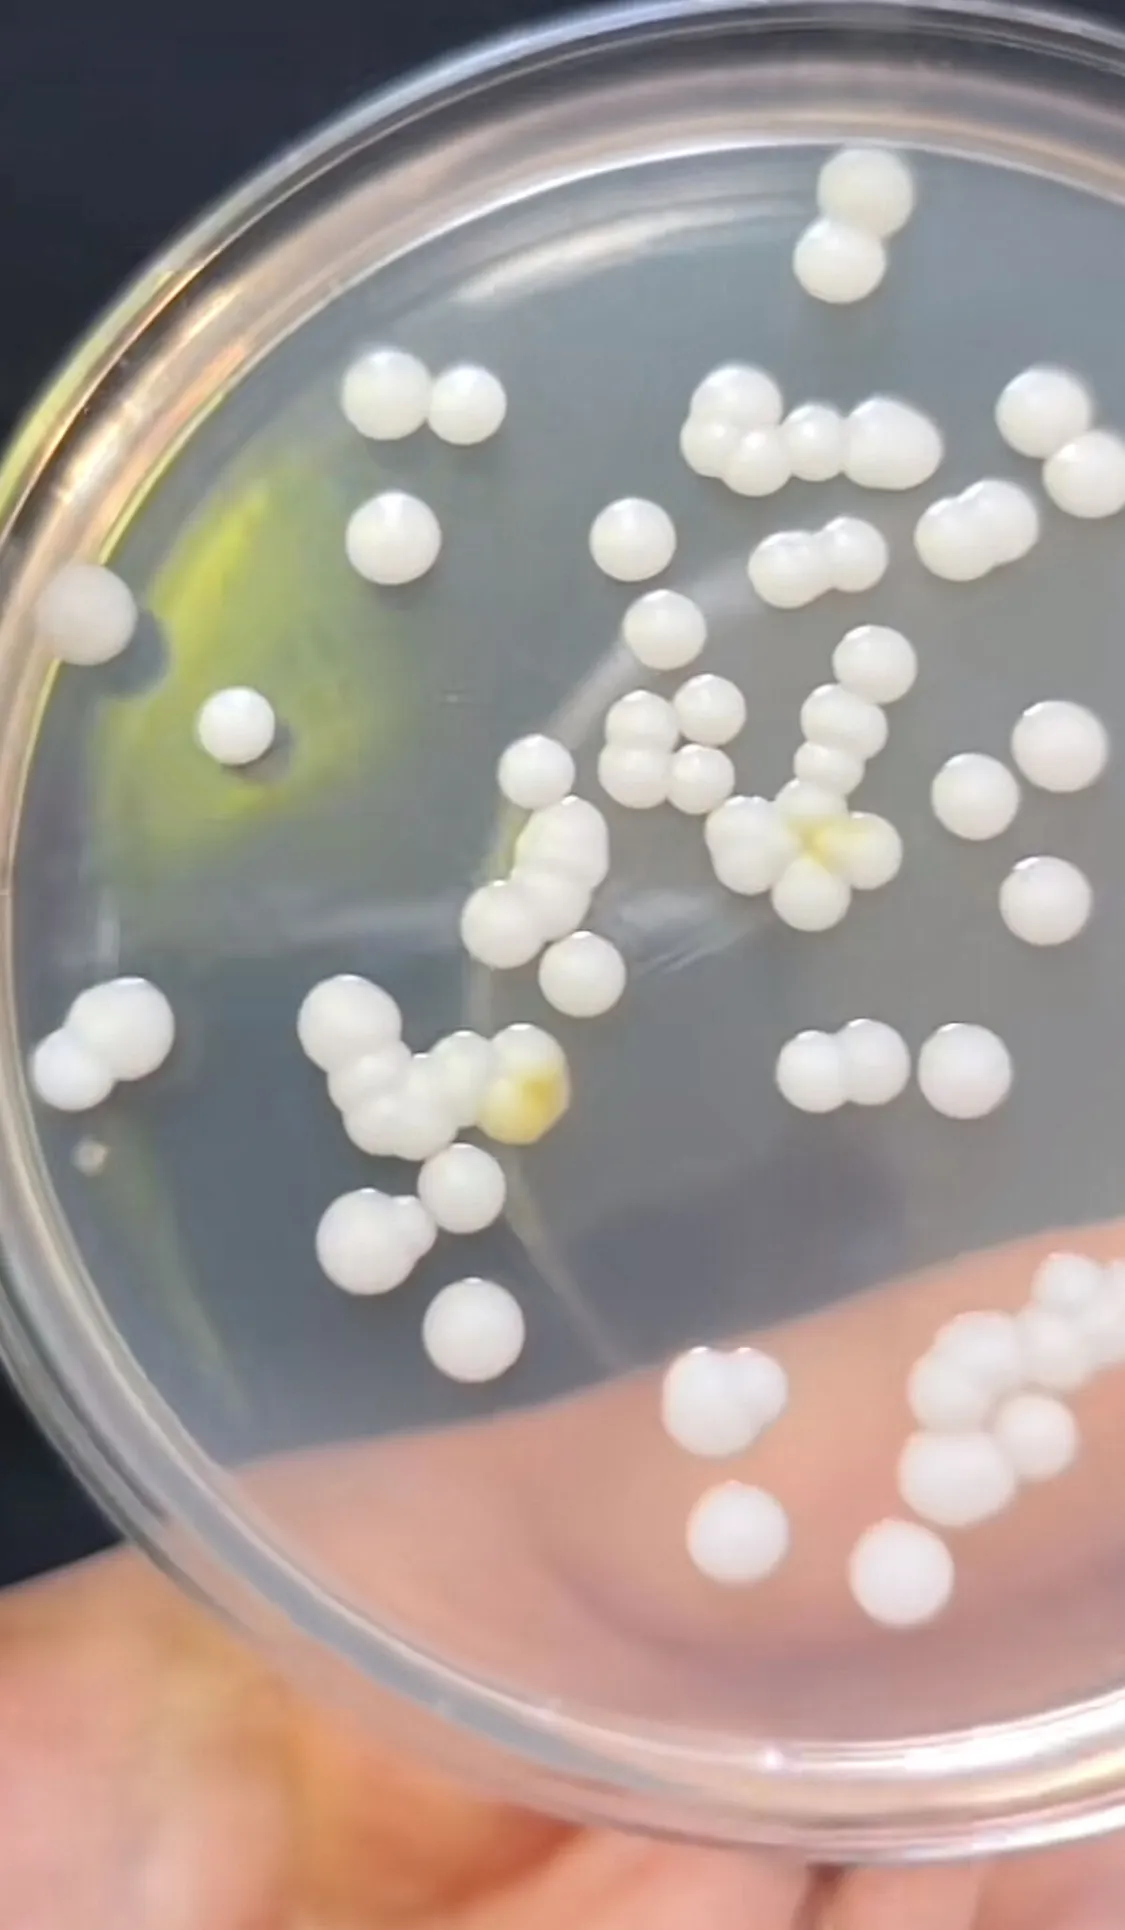
baktérium
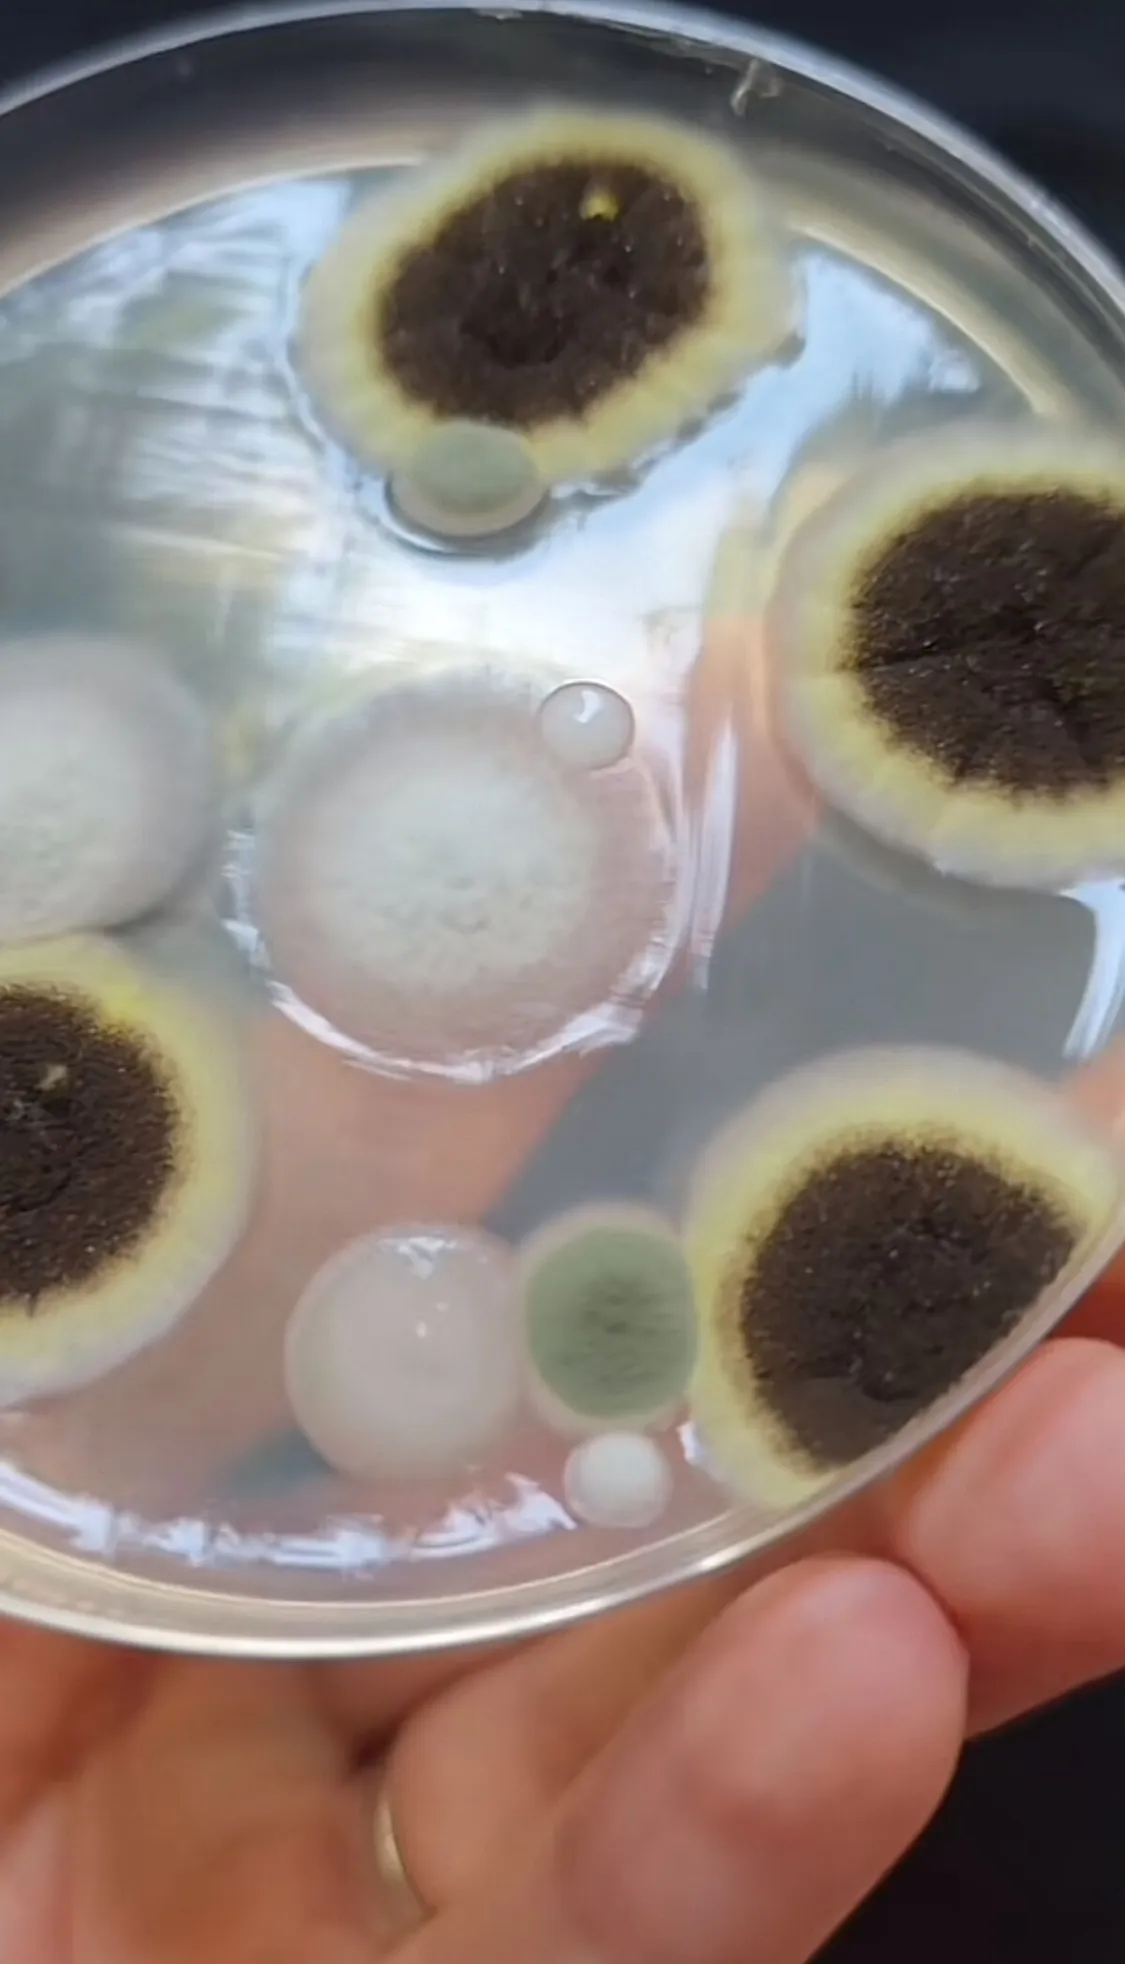

Itt a babák nagy bacitesztje: a cumi, vagy a játék hordoz több baktériumot? Most kiderül!
A TikTok kedvenc növényorvosa górcső alá vette a babacumit és ababajátékot. Az eredmény megdöbbentő. Nem hiszed, el, hogy min volt több baktérium.
Gyuris Rita, a TikTok kedvenc növényorvosa rendszeresen mutat be érdekes kísérleteket. Szemléltette már azt, hogy mennyi baktérium leselkedik ránk a szotyi héjáról, hogy mik élnek a mosógépünkben , vagy azt, hogy mit rejt valójában a csomós fűszerpaprika. Most azt tesztelte, hogy a baba cumija vagy a játéka a szennyezettebb. Az eredmény megdöbbentő.
„Nézzük meg, hogy a cumin, vagy a gyerekjátékon van több baktérium” – kezdte TikTok videóját
Először a cumiról vett mintát, a mintavevő pálcával majd egy speciális táptalajra, úgynevezett agar lemezre helyezte; azután a kislánya egyik kedvenc játékáról, egy plüss lepkéről vett mintát.
A cumin rengeteg baktérium volt
Három nap után a cumiról vett mintán pici baktériumkolóniát és egy gombatelepet talált.
„Fehér baktériumfaj az uralkodó a táptalajon” – jegyezte meg Rita. A pontosabb meghatározásukhoz további kísérletek lennének szükségesek.
Én nem nyalom le a cumit és nem csak azért, mert ezek nőttek fel rajta - ami várható volt-, hanem azért, mert a saját kórokozóinkat is átadhatjuk a gyereknek
- mondta a növényorvos.
A játékon a gombák voltak többségben
A játékról vett mintát is kielemezte.
Érdekes, hogy majdnem mind gombatelep, egy-egy baktériumkolónia van csak. Gombákból három- négyféle, baktériumból pedig hasonló fehéres, mint ami a cumin is volt
- állapította meg, hozzátéve:
„A játékokat időközönként ki szoktuk mosni, de mégis csak a földön vannak. Nem szabad megfeledkeznünk arról a tényről, hogy a baktériumok és a gombák az életünk részei és fontos szerepet töltenek be, elsősorban azok, melyek nem kórokozók.”






